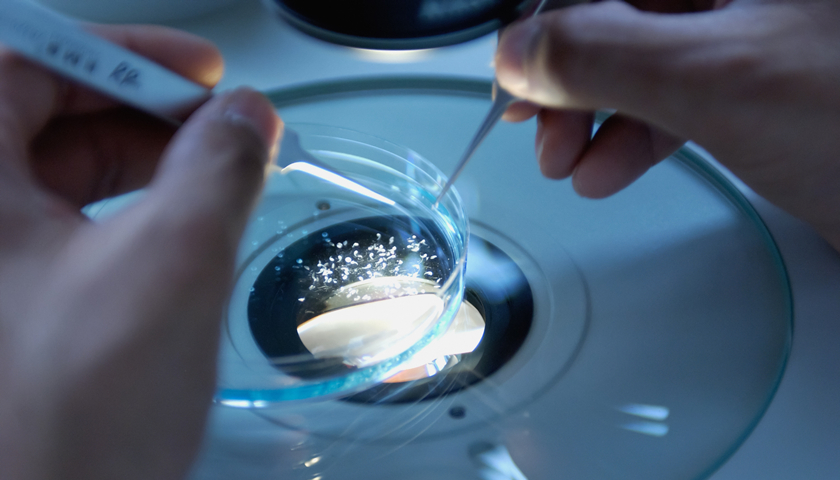

文|融中财经 顾白
编辑|吾人
“我们现在看的很多合成生物项目,过去都无人问津,今天却被众多投资人穷追不舍,其中不乏头部机构。”北京某机构早期投资人告诉融中财经(ID:thecapital)。
进入2022年,合成生物俨然成为创投圈的又一热点,高瓴起码出手4家相关企业,红杉、经纬、 峰瑞资本、光速中国、碧桂园等众多明星机构纷纷入局。
据融中不完全统计,2010-2022年,合成生物学全球共发生约700起投融资事件,仅2020年,全球合成生物学领域企业获得投融资468亿元,是2019年的2.5倍。2021年,上半年融资额达到578亿元,同比增长198.8%,超过2020年全年的融资额。而第三季度,投向合成生物学初创企业的资金高达61亿美元,增幅高达33%。

合成生物的发展其实由来已久,却在近几年才开始高速发展,成为创投圈“新宠”。
一方面,合成生物被称为是继分子生物学革命、“人类基因组计划”之后的“第三次生物技术革命”,无论医疗、消费、食品、新材料、甚至农业、美妆,一夕之间,似乎“一切皆可合成生物”。光速中国高健凯就表示:世界上60%的东西全部都可以用生物合成的方式重新做一遍,这是巨大的机会。
由此,也诞生了多家创新企业,包括凯赛生物(688065.SH)、华恒生物(688639.SH)、华熙生物(688363.SH)、弈柯莱生物、蓝晶微生物、恩和生物、酶赛生物、合生基因、丰原生物等。
然而,另一方面,在实际商业化过程中,要攻克的技术难关,远远要比任何一个项目融资时PPT中所提到的潜在风险要多得多。对于投资人而言始终是不小的挑战。
01、一周就决定投资,否则就抢不到份额
“最近,有不少投资人着急要和我见面,想要了解下合成生物学内容。”中国科学院院士、分子植物科学研究员赵国屏对媒体表示。
作为生命科学领域一门新兴的交叉科学,合成生物学其实已经发展很久。早在2000年,库尔等学者在美国化学年会上再一次用“合成生物学”描述生物系统中非天然存在的功能性有机分子合成,至此,合成生物学概念才被学术界公认并受到关注。2021年上半年,两家明星独角兽企业(Zymergen、Ginkgo)相继敲钟上市,间接为合成生物再添了一把猛火。
今天,各类投资机构对合成生物项目的竞争可以说十分激烈,很多投资人看完之后甚至不到一周时间就做了投资决策,“要不然根本抢不到份额。”同样也有投资人,对于看好的合成生物项目,从天使轮开始连续7轮加持,投资阶段逐渐从早期向A轮、B轮转移。
“要知道,以前(合成生物学)这样涉及交叉学科的项目,鲜少有人能听懂我们想干什么,甚至都不知道由哪个方向的投资人来看项目。”蓝晶微生物联合创始人&CEO张浩千回忆创业之初,“很感谢峰瑞资本,以及北大、清华校友基金的支持,帮助我们度过非常艰难的时期。”
这家成立于2016年的企业,直到三年后才进入发展的正轨,做了产品管线,产品性能通过了多个世界500强企业客户验证,并获得了多家企业的订单和意向订单。而公司的融资也走上了快车道。B轮融资总额达到15亿人民币。当然这都是后话。
之所以今天资本争相涌入,是因为合成生物被当做颠覆未来一切制造、重塑传统生产的技术。
对于合成生物产业,经纬张颖说过,这是一个综合大赛道,是行业的底层技术平台之一。在生物制药、细胞、基因治疗,食品消费、化工和现代农业等领域都有大量潜在落地场景。
从目前市场投资类别来看,主要集中在医疗健康、可再生能源、可降解塑料、生物合成化学品等领域。从应用层看,生物体设计与自动化平台型公司、提供赋能技术型公司这两类更受青睐,比如国内的蓝晶微生物、弈柯莱生物、恩和生物、瑞德林生物、迪赢生物等企业纷纷获得了高瓴、峰瑞、淡马锡、巴斯夫创投等知名机构加持。

02、万能皆可“合成”,碳中和带来更多创业机遇
从近5年,资本市场对合成生物的投资来看,主要集中在技术应用层面。
从产业链布局来看,主要涉及两类公司:一类是实现从基因编辑到产品落地的全产业链公司,既有合成生物学技术储备,又有市场化产品;另一类是以服务为主,提供基因编辑和细胞工厂的研发型公司,业务以提供合成生物学技术支持为主,产品以代工厂生产为主。
根据CB Insights测算,合成生物学的市场空间增速正逐步加快,预计2019-2024年,全球合成生物学市场中,复合年增长率将达到28.8%。其中,食品和饮料领域的规模复合增速排名首位,达64.6%,工业化学品市场空间将超过350亿元。无疑,合成生物学正在呈现爆发性增长。

资本市场也陆续关注合成生物学食品开发领域。
2021年,合成生物在食品&食品配料领域的投资占比约13%,全球合成生物市场食品领域融资额排名前十初创公司中,有7家公司是利用细胞培养技术生产肉类。
细胞培养肉是用动物干细胞体外培养而生产的肌肉组织,是一种全新的肉类生产技术,简单的说就是“不用养猪可以生产出猪肉”。 周子未来也是国内最早开展细胞培养肉研发的科技企业,获得了包括高瓴创投、经纬创投、南京创新投资集团等多家机构投资。
再以昌进生物这家公司来看,从自然界中寻找能作为人类新型食物来源的微生物,在高通量筛选、定向诱变、基因编辑等多个维度,建立独特的细胞工厂,实现蛋白质等重要营养物质的合成,能够为人们提供更安全、更低碳的蛋白质来源。
作为昌进生物的投资人,高瓴创始合伙人李良表示,替代蛋白方向的技术攻坚,不但能改变人类蛋白质的供给和生产方式,同时对于实现碳中和有重大前瞻意义。
事实上,“双碳”背景下,生物技术的应用可以降低工业过程能耗15-80%,原料消耗35%-75%,减少空气污染50%-90%,水污染33%-80%。换句话说,使用可再生原料替代不可再生能源必然是未来趋势,合成生物学也是实现生物质能源高效利用的理想手段。
“碳中和目标下,合成生物学一个非常有市场的应用方向就是传统化工材料的替代,而且在中国也有足够大的市场。”峰瑞资本创始合伙人李丰也对融中财经表示,“长期来看,要在中国实现碳中和,终究绕不过钢铁、水泥、塑料制造这三大项。合成生物学,简单来讲就是用菌、酶或者微生物来完成碳链的分解转移过程。这个过程里就有非常多创业机会。”
除了之外,李丰还对记者强调,这两年有一个特殊的背景,全球货币超发带来了全球性通胀,进而引发大宗商品的价格上涨。石油价格的上涨会导致石化产品价格水涨船高。原本合成生物学制造出来的石化产品替代品的价格是要高于石化产品的,而受大宗商品价格上涨影响,“绿色溢价”会相对降低,甚至出现“绿色平价”。所以可以判断,合成生物学接下来会迎来一个更加特殊且巨大的市场机遇。
03、科学家才是这场生物革命的C位
合成生物学包含了计算机科学、基因编辑和基因测序等跨领域的多学科。
“工程技术带来的生物科技革命还处在非常早期的阶段,国内外不超过10家上市公司,可借鉴的成熟经验也比较少。”高瓴张磊就提出,投资人要深入思考,在(合成生物学)价值链上如何做创新、如何落地?如何发挥科学家精神和企业家精神?因为从基础科研到产业化应用,从实验室到广袤的市场,诸多瓶颈需要突破,要迈过创新的死亡谷,绝非易事。”
2021年以来,高瓴围绕合成生物学密集布局,其中超过10家都是初创企业,占绝大多数,这中间又有超过一半公司是科学家创业、科学成果转化的结晶。
我们仍以蓝晶微生物为例,其创始人团队是北大博士和清华博士(联合创始人兼CEO张浩千是北京大学整合生命科学博士;另一位联合创始人、总裁李腾是清华大学生物材料学博士),之前,清华的一位教授也在团队,仅研究可降解塑料这件事情至少就有十几年技术能力积累。
高瓴表示,“在生物科技革命这场浪潮中,科学家才是主力军,要尊重科学家,让科学家坐C位,完成来自实验室的科研成果转化。要让科学家把主要精力投进科技创新和研发活动中,让他们做自己擅长的事情,解决核心问题,把融资、商业模式、销售、知识产权等商务上的事情交给专业人士来做,从而提高科技成果的转化效率。”
04、退出预期不要太乐观
过去两年,合成生物领域,涌现了大量初创企业。这个赛道需要大量能落地的技术,从实验室走到工业界,系统性地打通产业转换的路径,这是我们非常期待的。
“不过,对于合成生物学公司来说,关键的产业化节点是能否做到成本具有竞争优势”,凯赛生物的董事长刘修才说过,“只有产品过硬的公司才能持续发展。”
随着合成生物学概念的推广,国内外涌现出了大批合成生物学公司,在医药、农业、食品、材料、精细化学品等各个领域进行颠覆式创新,然而技术突破及产业化落地仍是其核心发展瓶颈。
“合成生物学最主要的任务,是要按人们的需求,设计出相应的‘产品’,即分子机器、细胞工厂、新型药物等。但实现这一目标的最大科学技术瓶颈,是理性设计能力太差,其背后是对非线性的复杂的生命系统,从分子到细胞再到个体的多层次功能和规律的科学认识不到位。”这是中科院院士赵国屏对合成生物学给出的冷思考。
“一些技术研发的进度永远比想象的慢,上游的菌种培育、基因改造、酶种选择、中游的环境控制、下游的提纯技术等全都是没有现成know-how的坑。投资人们别对项目退出预期周期不要太乐观。”某天使投资人同样表达了对投资合成生物学的担忧。
日前,“人工智能预测蛋白质结构”位列国际学术期刊《科学》2021年度十大科学突破之首。未来,与人工智能的融合,可能会是合成生物学的一个发展方向;而细胞机器人和混合细胞电子系统的出现,则为集成电路与合成生物学的交叉,提供了新思路。
简单来讲,任何新技术新产业的发展都必然要经历时间的打磨。如果将目光以十年为单位放远,我们相信,合成生物学必然将描绘出一个更可持续、更有无穷潜力的未来画像。
*融中财经(ID:thecapital)



评论